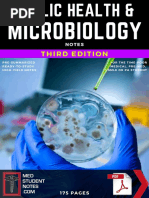

naproxen
(na prox' en)
naproxen
Apo-Naproxen (CAN), EC-Naprosyn, Naprelan, Naprosyn, Naxen (CAN),
Novo-Naprox (CAN)
naproxen sodium
Aleve, Anaprox, Anaprox DS, Apo-Napro-Na (CAN), Synflex (CAN)
Pregnancy Category B (first and second trimesters)
Pregnancy Category D (third trimester)
Drug classes
NSAID
Analgesic (nonopioid)
Therapeutic actions
Analgesic, anti-inflammatory, and antipyretic activities largely related to inhibition of
prostaglandin synthesis; exact mechanisms of action are not known.
Indications
• Mild to moderate pain
• Treatment of primary dysmenorrhea, rheumatoid arthritis, osteoarthritis,
ankylosing spondylitis, tendinitis, bursitis, acute gout
• OTC use: Temporary relief of minor aches and pains associated with the common
cold, headache, toothache, muscular aches, backache, minor pain of arthritis, pain
of menstrual cramps, reduction of fever
• Naproxen only: Treatment of juvenile arthritis
Contraindications and cautions
• Contraindicated with allergy to naproxen, salicylates, other NSAIDs; pregnancy;
lactation.
• Use cautiously with asthma, chronic urticaria, CV dysfunction; hypertension; GI
bleeding; peptic ulcer; impaired hepatic or renal function.
Available forms
Tablets—250, 375, 500 mg; 220, 275, 500 mg (as naproxen sodium); DR tablets—375,
500 mg; CR tablets—375, 500 mg; suspension—125 mg/5 mL
Dosages
Do not exceed 1,500 mg/day (1,375 mg/day naproxen sodium).
ADULTS
• Rheumatoid arthritis or osteoarthritis, ankylosing spondylitis:
Delayed-release (EC-Naprosyn)
�375–500 mg PO bid.
Controlled-release (Naprelan)
750–1,000 mg PO daily.
Naproxen sodium
275–550 mg bid PO. May increase to 1.65 g/day for a limited period.
• Acute gout:
Controlled-release (Naprelan)
1,000–1,500 mg PO daily.
Naproxen sodium
825 mg PO followed by 275 mg q 8 hr until the attack subsides.
• Mild to moderate pain:
Controlled-release (Naprelan)
1,000 mg PO daily.
Naproxen sodium
550 mg PO followed by 275 mg q 6–8 hr.
OTC
200 mg PO q 8–12 hr with a full glass of liquid while symptoms persist. Do not exceed
600 mg in 24 hr.
PEDIATRIC PATIENTS
• Juvenile arthritis:
Naproxen
10 mg/kg/day given in 2 divided doses.
Naproxen sodium
Safety and efficacy not established.
OTC
Do not give to children < 12 yr unless under advice of physician.
GERIATRIC PATIENTS
Do not take > 200 mg q 12 hr PO.
Pharmacokinetics
Drug Onset Peak Duration
Naproxen 1 hr 2–4 hr < 7 hr
Naproxen sodium 1 hr 1–2 hr < 7 hr
Metabolism: Hepatic; T1/2: 12–15 hr
Distribution: Crosses placenta; enters breast milk
Excretion: Urine
Adverse effects
• CNS: Headache, dizziness, somnolence, insomnia, fatigue, tiredness, dizziness,
tinnitus, ophthalmic effects
• Dermatologic: Rash, pruritus, sweating, dry mucous membranes, stomatitis
• GI: Nausea, dyspepsia, GI pain, diarrhea, vomiting, constipation, flatulence
• GU: Dysuria, renal impairment, including renal failure, interstitial nephritis,
hematuria
� • Hematologic: Bleeding, platelet inhibition with higher doses, neutropenia,
eosinophilia, leukopenia, pancytopenia, thrombocytopenia, agranulocytosis,
granulocytopenia, aplastic anemia, decreased Hgb or Hct, bone marrow
depression, menorrhagia
• Respiratory: Dyspnea, hemoptysis, pharyngitis, bronchospasm, rhinitis
• Other: Peripheral edema, anaphylactoid reactions to anaphylactic shock
Interactions
Drug-drug
• Increased serum lithium levels and risk of toxicity with naproxen
Drug-lab test
• Falsely increased values for urinary 17-ketogenic steroids; discontinue naproxen
therapy for 72 hr before adrenal function tests
• Inaccurate measurement of urinary 5-hydroxyindoleacetic acid
Nursing considerations
Assessment
• History: Allergy to naproxen, salicylates, other NSAIDs; asthma, chronic
urticaria, CV dysfunction; hypertension; GI bleeding; peptic ulcer; impaired
hepatic or renal function; pregnancy; lactation
• Physical: Skin color and lesions; orientation, reflexes, ophthalmologic and
audiometric evaluation, peripheral sensation; P, edema; R, adventitious sounds;
liver evaluation; CBC, clotting times, renal and liver function tests; serum
electrolytes; stool guaiac
Interventions
• Give with food or after meals if GI upset occurs.
• Arrange for periodic ophthalmologic examination during long-term therapy.
• If overdose occurs, institute emergency procedures—gastric lavage, induction of
emesis, supportive therapy.
Teaching points
• Take drug with food or meals if GI upset occurs; take only the prescribed dosage.
• Dizziness, drowsiness can occur (avoid driving or the use of dangerous
machinery).
• Report sore throat; fever; rash; itching; weight gain; swelling in ankles or fingers;
changes in vision; black, tarry stools.
Adverse effects in Italic are most common; those in Bold are life-threatening.